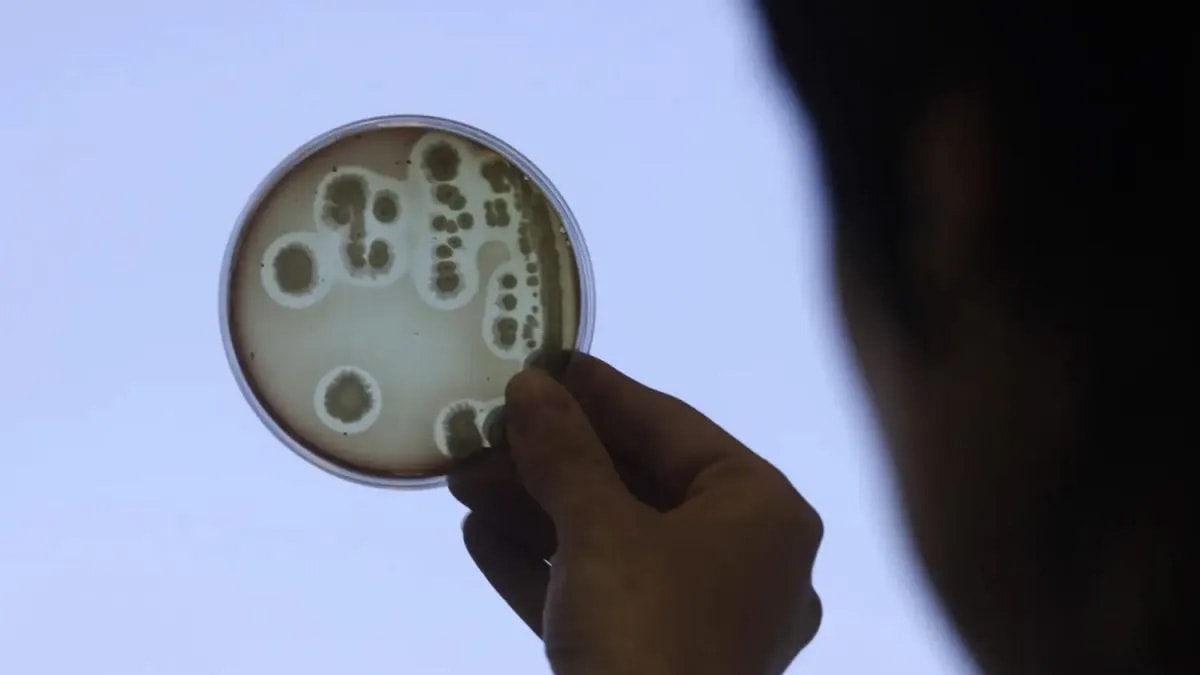

Hemen her yüzeyde bulunan ve çeşitli hastalıklara neden olan bakteriler hayati tehlikelere yol açabilecek kadar tehlikeli olabiliyorlarmış.
Milyonlarca insan bakteriyel enfeksiyonlar nedeniyle hayatlarını kaybederken en tehlikeli olan bakteri çeşitleri merak ediliyor.
Dünya Sağlık Örgütü'nün (DSÖ) tahminlerine göre, bakteriyel antibiyotik direnci, 2019 yılında dünya genelinde 1,27 milyon doğrudan ölüme yol açtı. Ayrıca bu tür dirençlerle bağlantılı ölümlerin toplam sayısının yaklaşık 4,95 milyon olduğu tahmin ediliyor.
İlaçlara karşı direnç gösterebilen ve hayati tehlike oluşturabilecek en tehlikeli bakteriler listelendi. İşte, antibiyotiklere karşı direnç gösteren tehlikeli bakteriler…

DÜNYANIN EN TEHLİKELİ 8 BAKTERİSİ
1. KLEBSİELLA PNEUMONİAE
· Kaynak: İnsan bağırsakları ve dışkılarında bulunur.
· Hastalıklar: Zatürre, kan zehirlenmesi, yara enfeksiyonları ve menenjit.
· Direnç: Karbapenemlere dirençli, bu da tedavi seçeneklerini sınırlar.
2. ESCHERİCHİA COLİ (E. COLİ)
· Kaynak: İnsan ve hayvan bağırsaklarında doğal olarak bulunur.
· Hastalıklar: İshal, idrar yolu enfeksiyonları, zatürre ve sepsis.
· Direnç: Üçüncü nesil sefalosporinlere ve karbapenemlere dirençli.

3. ACİNETOBACTER BAUMANNİİ
· Kaynak: Hastane enfeksiyonlarıyla bağlantılıdır.
· Hastalıklar: Kan zehirlenmesi, zatürre ve yara enfeksiyonları.
· Direnç: Karbapenemlere dirençli.
4. MYCOBACTERİUM TUBERCULOSİS
· Kaynak: Tüberkülozun (TB) etken maddesi.
· Hastalıklar: Tüberküloz
· Direnç: Rifampisin gibi ilaçlara direnç geliştirmiştir.

5. SALMONELLA TYPHİ
· Kaynak: Tifo hastalığına neden olur.
· Hastalıklar: Ateş ve enfeksiyonlar.
· Direnç: Florokinolonlara dirençlidir.
6. SHİGELLA TÜRLERİ
· Kaynak: Kirli gıda ve su yoluyla bulaşır.
· Hastalıklar: İshal, karın ağrısı ve ateş.
· Direnç: Florokinolonlara dirençlidir.

7. ENTEROCOCCUS FAECİUM
· Kaynak: Bağırsak florasında bulunur.
· Hastalıklar: İdrar yolu enfeksiyonları ve sinir sistemi enfeksiyonları.
· Direnç: Vankomisine dirençlidir.
8. PSEUDOMONAS AERUGİNOSA
· Kaynak: Ameliyat sonrası enfeksiyonlara neden olur.
· Hastalıklar: Kan, akciğer ve idrar yolu enfeksiyonları.
· Direnç: Karbapenemlere dirençlidir.





